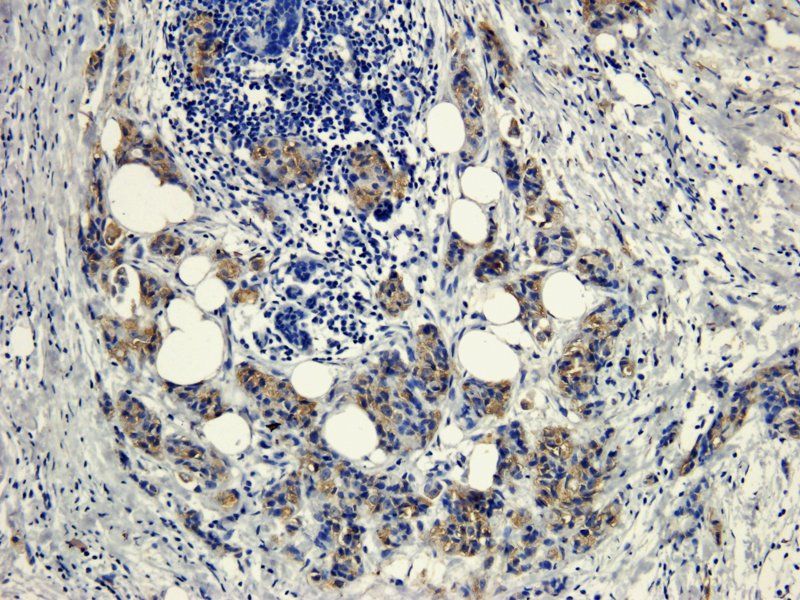
CD105 antibody

You have no items in your shopping cart.
IF, IHC, WB
Human, Mouse, Rat
Rabbit
Polyclonal
Unconjugated
100 μl, 25 μl- CD63 Antibody / LAMP-3 [orb749338]
FACS, IF, IHC-P, WB
Human, Mouse
Mouse
Monoclonal
Unconjugated
100 μg, 20 μg - Beta-2 Microglobulin Antibody [orb749756]
FACS, IF, IHC-P, WB
Human
Mouse
Monoclonal
Unconjugated
100 μg, 20 μg - CD63 Antibody / LAMP-3 [orb2637615]
FACS, IF, IHC-P, WB
Human, Mouse
Mouse
Monoclonal
Unconjugated
100 μg - EpCAM Antibody / Extracellular domain [orb2640454]
FACS, IF, IHC-P, WB
Canine, Feline, Human
Mouse
Monoclonal
Unconjugated
100 μg - Featured
beta Actin antibody [orb181785]Featured
ELISA, ICC, IF, IHC-P, WB
Human, Mouse
Rabbit
Polyclonal
Unconjugated
100 μg - Featured
HMGCR (phospho-Ser872) antibody [orb251472]Featured
IHC-P
Bovine, Canine, Gallus, Human, Mouse, Porcine, Rat
Rabbit
Polyclonal
Unconjugated
100 μg - Featured

- Featured
CXCR1 antibody [orb10487]Featured
ICC, IF, IHC-P, WB
Rabbit
Polyclonal
Unconjugated
100 μg, 20 μg (trial size), 5 μg (trial size)